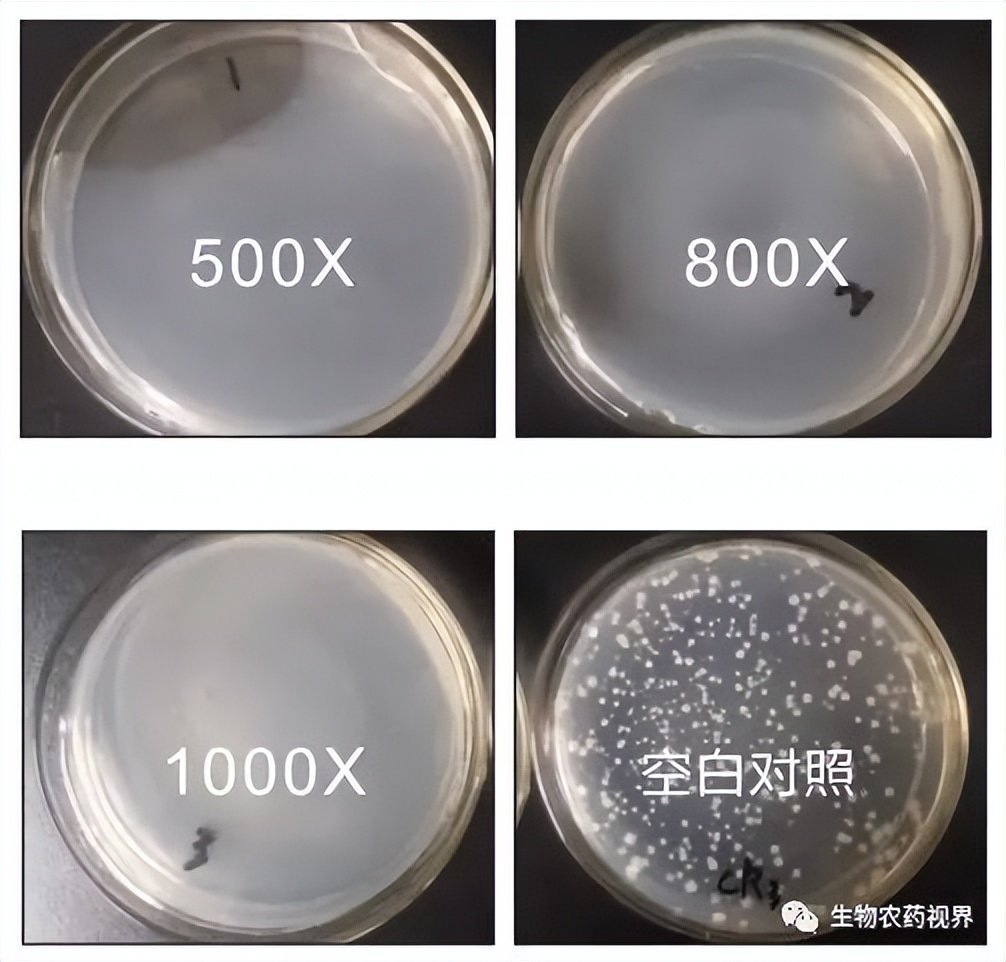

近年来,受种植业结构调整、极端天气频发、新型病害流行等因素影响,细菌性病害在中国危害越来越严重。据2018年相关报道显示,目前国内细菌性病害发生面积在1.2亿亩次,并呈现逐年增加的趋势,其为害程度已经超越病毒,成为仅次于真菌的第二大病原物。
但是针对细菌性病害的产品数量仅占防治病害类药剂的2.6%,且同质化严重,无机铜类、有机铜类、抗生素类等长期使用造成病害抗性倍增,同时带来农药残留超标,严重影响农产品和食品的质量安全,影响人类健康。

细菌性病害传播途径多样,在湿度较高环境中就可以直接通过植物的气孔、皮孔、伤口等侵入植物体内;同时由于农户不会识别细菌性病害,因此常常不能对症下药,一旦错过细菌性病害的最佳防治时期,病害就会爆发性蔓延,造成极大的损失。
目前,用于防治细菌性病害的药剂有很多种,如抗生素类、有机(无机)铜制剂类、噻唑类、枯草芽孢杆菌等生物制剂。但是由于实际生产中农户往往把握不住最佳施药时期以及习惯在爆发期连续用药,同种药剂连用多次等不科学的施药习惯,加上市场防治细菌性病害的相关药剂或多或少都还存在一些不足或问题,导致农业生产中防治细菌性病害时常常出现“效果不好”,“打不住”,“抗药性上升”等等一系列问题。
细菌性病害抗药性飚增,大蒜素或为解决良方
大蒜素是从大蒜鳞茎中提取的生物活性成分的总称。大蒜素是一种绿色、安全的抑菌物质,而目前也已经证明其对于农业生产上的多种病害具有抑制作用,其中对于细菌性病害的抑制效果最好,杀菌谱最广。
大蒜素抑菌原理
大蒜素中最为主要的活性成分是一种二烯丙基二硫化物,这类物质能穿过细菌病害的细胞膜进入细胞质中,对含巯基的化合物(某种蛋白质)发生竞争性抑制使其失活,导致细菌不能进行生物氧化作用,从而破坏新陈代谢,达到抑制病菌的生长和繁殖的作用。
由于大蒜素特别的杀菌机理,病菌不易产生抗药性,大蒜素使用后在植物中的残留量远低于人体每日从大蒜中摄取量,在自然环境中易降解,是一种绿色环保、安全健康的“绿色农药”。
成都新朝阳的大蒜素通过“共提取”技术提取而成
CE大蒜素,作物细菌性病害新选择
目前国内用于农业上登记的大蒜素有成都新朝阳作物科学股份有限公司首家登记,分别登记有大蒜素的母药和5%微乳剂。登记的防治对象正是作物细菌性病害。根据农业部全国农技推广中心的试验数据表明,成都新朝阳的大蒜素在防治甘蓝软腐病、黄瓜细菌性角斑病、三七黑斑病、川芎根腐病、甘薯黑斑病、柑橘溃疡病、水稻细菌性细条病等等植物病害时防效能达到70%~90%。
防治细菌性病害,防效可与市场上常用药剂媲美
室内试验中大蒜素对细菌性病菌的抑菌效果
5%CE大蒜素微乳剂对柑橘溃疡病、烟草青枯病室内效果
5%CE大蒜素微乳剂对水稻细菌性条斑病室内效果
综上,5%CE大蒜素微乳剂单剂在500倍、1000倍以及2000倍浓度下对柑橘溃疡病、烟草青枯病和水稻细菌性条斑病三种病原菌的抑菌效果均要优于对照药剂或者与对照药剂相当。对烟草青枯菌最高抑菌率可达97.81%,对柑橘溃疡最佳抑菌率可达97.18%;对水稻细菌性条斑最佳抑菌率可达74.04%,且对作物植株生长有一定促进作用。
成都新朝阳大蒜素:作物细菌性病害新选择。细菌性病害防治效果好,防效可与目前市面上相关药剂媲美;不易产生抗药性,安全环保,无农残风险。
CE大蒜素应用技术
总结
在当前细菌性病害发生加重,防治难度大的条件下,细菌性病害“以防为主”是方向。
推荐各位农民朋友使用“大蒜素+化学药剂”的方案防治细菌性病害,二者协同防治,增效显著,可有效提高细菌病害防效,延缓其他杀菌剂的抗药性产生具有重大意义;同时,“大蒜素+化学药剂”方案在促进生长、提高免疫等方面上具有巨大优势。大蒜素能够促进作物微伤口的修复和植株生长,提升作物抗逆能力,减少病菌侵染。